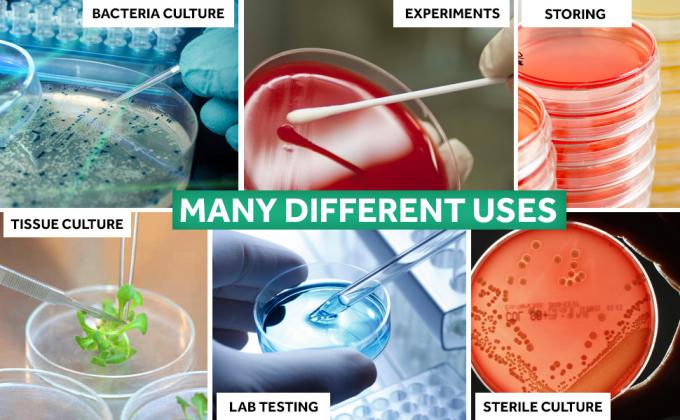
petree dish petri dish 90mm petri dish with lids metal petri dish petri dish  peachtree dish

Plastic petri dish:
Plastic embedding cassette
Pipette tips:
Spectrometer Cuvette
PCR tube strips:
Plastic Beaker
Plastic Funnel:
Plastic Measuring Cup
Plastic Burette Clamp:
Plastic Standard Joint Stopcock
Plastic Reagent Bottle:
GL14 Hose Barb
Conical Head Clip:
Reagent Bottle
WASHING BOTTLE:
LABORATORY PLASTICWARE
CONE:
MEASURING CYLINER
EVAPRATING:
CRYSTALLIZING
amniotic hook:
plastic funnel
plastic washing bottle:
identification band
Plastic measuring cylinder:
Plastic measuring cup
Plastic beaker:
Plastic reagent bottle
Cell culture bottle:
Umbilical cord clamp
Plastic flask:
Syringe filter
Swab:
Pipette
Centrifuge tube:
Cell series
Culture plate:
Specimen Container
Inolulation loop:
cryovial tube
Plastic test tube:
VTM sample tube
أنبوب جمع الدم:
مغلق أنبوب اختبار بلاستيكي
Cell spreader:
cervical brushes
Cuvette:
Nasal speculum
Vaginal speculum:
Tweezers forceps
Plastic box:
Pipette tip
البيبطة المصلية:
ماصة باستير
Beaker:
Measuring cylinder
PCR tube:
Cryovial tube
Syringe filter:
Bottle top filter
Spin column:
Specimen container
Thermometers:
digial scale

 يجب أن تكون رسالتك بين 20-3000 حرف!
يجب أن تكون رسالتك بين 20-3000 حرف! من فضلك تفقد بريدك الالكتروني!
من فضلك تفقد بريدك الالكتروني!  يجب أن تكون رسالتك بين 20-3000 حرف!
يجب أن تكون رسالتك بين 20-3000 حرف! من فضلك تفقد بريدك الالكتروني!
من فضلك تفقد بريدك الالكتروني!